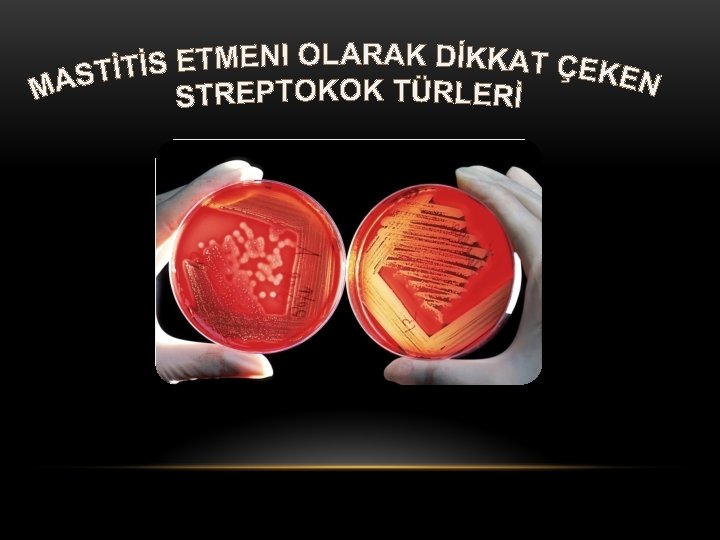

sekil Streptococcus pyogenes v Streptokoklar doada olduka yaygn

- Slides: 25
sekil: Streptococcus pyogenes
v Streptokoklar doğada oldukça yaygın olup insan vücudu normal florasında ve saprofit olarak süt ve ürünlerimde bulunur. v Patojen olan türler ise insan ve hayvanlarda değişik enfeksiyonlara sebep olur. v Hayvanlarda mastitis etmenlerinin en önemlilerindendir. v Patojen ve saprofit özellikte olan Streptococcus’lar hemoliz yapma özellikleri, çoğalma sıcaklıkları, önemli bazı biyokimyasal özellikleri ile antijen yapılarına göre Sherman tarafından 4 gruba ayrılmıştır. Sherman‘ın yaptığı gruplandırma bir sonraki slaytta verilmiştir. Çizelge 1: Streptococcus genusuna giren gruplar ve temsilci türleri (Serter ve Bilgehan, 1978) (Tabloya geçmek için tıklayınız)
Grup ve Türlerin isimleri Lancefield Grup Hemoliz Konukçu PİYOJEN GRUP Streptococcus pyogenes A β AT, İNSAN Streptococcus equi C β İNSAN, HAYVAN Streptococcus equisimilis C β SIĞIR Streptococcus agalactiae B β İNSAN Streptococcus salivarius K - İNSAN Streptococcus mitis - α İNSAN Streptococcus bovis D - SIĞIR Enterococcus faecalis D β İNSAN, HAYVAN Enterococcus faecalis spp. liquefasciens D β, α İNSAN, HAYVAN Enterococcus faecalis zymogenes D β, α İNSAN, HAYVAN Enterococcus faecium D β, α İNSAN, HAYVAN N α VİRİDANS GRUP ENTEROKOK GRUP LAKTİK GRUBU Lactococcus lactis spp. lactis SÜT VE
v Streptococcus türleri sporsuz ve hareketsizdir. v Katalaz(-), aerob ve fakültatif anaerobtur. v β hemolitiktirler. v Genel olarak bunlar 10 -45°C’ de, %6, 5 Na. Cl içeren besi yerlerinde, 9, 6 p. H’da ve %0, 1 metilen mavisi bulunan sütte üreyemezler v %40 safrada gelişmezler. v Genel olarak solunum sisteminde bulunurlar. v G(+) olup, kok şeklindedirler. v Zincir uzunlukları çevresel faktörlere bağlı olarak büyük değişiklik gösterir.
v Mastitis ile insanlarda hastaklıklara neden olan streptokoklar pyogen grup içinde yer alırlar. Pyogen grupta yer alan türler; Patojen olan bu bakteriler arasında en önemlileri; Ø Streptococcus pyogenes Ø Streptococcus agalactiae Ø Streptococcus dysgalactiae Streptococcus agalactiae aynı zamanda insan patojenidir. Septisemi ve menenjit gibi iki farklı hastalık oluşturabilen çok tehlikeli ve aynı zamanda yeni doğan enfeksiyonlarından sorumludur.
v En çok dış kısmındaki kapsül türlerine göre farklılaşan kimyasal bir bileşime sahiptir. v Streptococcus equi ve Streptococcus zooepidermicus’ ta kapsül hyaluronik asitten oluşur. Aynı şekilde mastitisli memeden izole edilen Streptococcus agalactiae ‘da kapsül antijeniktir ve serolojik olarak fark ise kapsül tipinin polyosidik oluşudur. v Çoğunda hyaluronik asit içeren bir kapsül bulunur. Kapsüller en iyi genç hücrelerde görülür ve fagozitoza engel olurlar v Lancefield sınıflandırılmasında A, B, C, D, E, F, G ve H gruplarında bulunan birçok streptokok türü pyogen grubu içinde yer almaktadır. v Streptococcus uberis diğerlerine göre daha sıklıkla izole edilen bir türdür. Daha seyrek olan Streptococcus bovis, Streptococcus faecium ve Streptococcus faecalis gibi türler mastitisli sütlerden izole edilmiştir. Son iki tür son isimlendirmede Enterococcus genusu içinde yer almaktadır. Özellikle insanlarda en sık enfeksiyona sebep olan Streptococcus pyogenes grubun önemli üyesidir.
Şekil 1. 1: Streptokok Hücresinin Antijenik Yapısı : a kapsül, hyalüronik asitten, b Hücre duvarının M, T, R protein antijenleri, c Agrubu streptokoklar için özel karbonhidretlar (ramnoz-N-asetil glukozamin)
1. 2 BİYOKİMYASAL ÖZELLİKLERİ Ø Genel olarak değişebilen anaerob ve mikroaerofil özellik gösterirler. Ø En iyi çoğaldıkları p. H derecesi 6, 8 -7, 4’dür. Ø Optimum gelişme sıcaklıkları 37°C olup 20 -40°C ler arasında da yaşamlarını sürdürürler. Ø Streptokoklar hemoliz yapma özelliklerine göre; i. β hemoliz (tam hemoliz yapanlar) ii. α hemoliz (yeşil renkli hemoliz yapanlar) iii. Hemoliz yapmayanlar (γ) olmak üzere başlıca 3 grupta toplanır. Ø İnsan ve hayvanlarda enfeksiyon meydana getiren streptokokların daha çok β hemoliz oluşturdukları bilinmektedir.
• Mastitis güncelliğini koruyan 100 yıllık bir patojendir. • Mastitisin önemli bir iltihaplanmaya işaret eden karakteristikleri acı, ateş, sertlik, kırmızı olarak tanımlanır. Bu, Nocord ve Mollereau (1884) keçi sütünden izole ettikleri ve onların Streptococcus mastitis contagiose ismini verdikleri, Kitt (1893)’tin Streptococcus agalactiae contagiosae diye isimlendirdiği bir bakterinin mastitis enfeksiyonunun nedeni olarak kanıtlanmıştır. • Yüzyıldır enfeksiyon kaynağı ortaya konulabilmesine rağmen mastitis hiçbir zaman kesin olarak tanımlanamamıştır. • Hayvancılığı gelişmiş birçok ülkede elde edilen yeni veriler yılda 5 hayvandan birinde meme enfeksiyonu olduğunu ortaya çıkarmıştır.
Bu enfeksiyonlar: • Süt üretiminde verimin düşmesine sebep olur. • Teknolojiye elverişliliği, hastalığın seyrine göre riske girer • Sütün kimyasal ve mikrobiyolojik kalitesinde bir düşme gözlenir. • Ürüne çevirme zorlaşır. • Prematüre doğumlar ortaya çıkar. • Süt hayvanı daima enfeksiyon kaynağı durumundadır. !! Böylece mastitisin sebep olduğu ekonomik kayıplar ve sıklığından dolayı, süt endüstrisinin geliştiği ülkelerde en önemli patojenik problem olarak kabul edilir. Şimdilerde süt işletmeleri tarafından süt üreticilerine süt parasının ödenmesinde somatik hücre sayısı(SHS) ölçümü ve tüketimi için bırakılan eşikler, sürülerdeki hayvanların sanitasyon koşullarını düzeltmek için çok önemli teşvikler oluşturuyor.
Ø Süt hayvanlarında mastitise neden olan bir streptokok türüdür. Ø İnsanlarda çok çeşitli, iltihaplı ve irinli yara ve hastalıklara sebep olur. Genellikle sağlıklı insanların dudak, ağız içi ve solunum yollarına lokalize olmuşlardır. Ø Kalabalık topluluklarda, örneğin okul kantinleri, hastaneler, tiyatrolar vs gibi yerlerin havasında bulunur. Str. pyogenes’in ışık Ø Kuvvetli β hemolitik özellik gösterir. mikroskobu görüntüsü. Ø Yuvarlak veya oval şeklinde görünürler. Ø Genellikle insanlardan hayvanlara geçer ve onlarda mastitis hastalığını oluştururlar. Bulaşık memeden süte ve ordan da tekrar insana geçer. Şekil: Str. pyogenes’in hücre yapısı
Str. pyogenes, insanlarda tonsilit, iskelet ağrıları, romatizma tipi ağrıların sebeplerindendir. Şekil: Bademcikte Tonsilit görünümü. Tonsilit bademcik iltihabı olarak bilinmektedir Bazı bebeklerde ve yetişkinlerde deri üzeri iltihaplı yaralara sebep olmaktadır. Bu rahatsızlıklar eritrojenik toksin gibi toksin faktörler tarafından oluşturulmaktadır.
Ø Genusunun birçok özelliğini taşır; hareketsiz, ovoid veya küresel hücreleri vardır. Ø Diplokok formda olduğu gibi uzun zincirler de oluşturabilirler. Ø Optimum gelişme sıcaklığı 37°C’dir. Ø İnsan kaynaklı suşları pigment meydana getirir. Sığır kaynaklılar ise pigment oluşturmazlar. Ø Sığırlara adapte olan suşlar β hemoliz yapar. β hemoliz ile birlikte CAMP testinde verdiği reaksiyon onun diğer türlerinden ayrılmasında önemli bir tanım kriteridir. Streptococcus agalactiae tiplerinin ayrımı: ÖZELLİKLER SIĞIR ORJİNLİ Streptococcus agalactiae’ nın elektron mikroskoptaki görüntüsü. İNSAN ORJİNLİ PİGMENT OLUŞUMU - + LAKTOZUN KULLANIMI + - SALİSİNİN KULLANIMI - + β GALAKTOZİDAZ ENZİM SENTEZİ + - BASİTRASİNE DUYARLILIK + - SÜTTE PIHTI OLUŞTURMA + - + Pozitif - Negati f
Ø Bakteri ilk olarak bebeklerden izole edilmiştir. Prematüre bebeklerde ve küçük çocuklarda enfeksiyona sebep olarak bilinmektedir. Ø Temelde insan ve sığır kaynaklı bir patojendir. Ø İnsanda daha çok sindirim sistemi, vajina, boşaltım sistemi daha seyrek olarak üst solunum yolu enfeksiyonlarına sebep olmaktadırlar. Ø Sığırlarda mastitise sebep olur. Bakterinin yerleşim yeri memelerdir. Ø İnsan ve sığır arasındaki geçişler memeden süte sütten insana şeklindedir. Şekil: Sığırlarda mastitis görünümü. Bu patojenin hastalık yapma özelliği, hemolisin, hyalüronidaz, deoksiribonükleaz, CAMP faktör, adezin ve adesiv özelliklerini arttıran faktörler ile antijen tipleri gibi virulans faktörlere göre değerlendirilmektedir.
Streptococcus agalactiae’nın Sığıra Bulaşması: • Mikroorganizma öncelikle meme lobunun alt kısmındaki meme başı ve kanallarına enfekte eder. • Meme başından iç kısımlara girerek dokulara tutunurlar ve çoğalarak alveollere geçerler. • Bakteriler tarafından üretilen toksinler epitelyum hücrelere zarar verir ve özellikle kan damarlarının geçirgenliklerini arttırırlar. • Bu arada doku hasarı olur ve lökositler salgı dokusundaki bakterilerle birlikte süt kanallarını tıkar ve sütün akışını azaltabilir. **** Bu birikim sonucunda inovülaston, yaralı doku oluşumu ile süt veriminde azalmalar ortaya çıkar. Bu durum gerektiği şekilde tedavi edilirse düzelmektedir. .
Şekil: Str. agalactiae’nin süt hayvanındaki yaşam döngüsü. Diğer mastitis etmeni streptokok türleri Streptococcus disgalactiae ve Streptococcus uberis, daha seyrek rastlanan Enterococcus faecalis ve Enterococcus faecium’dur. Bunlara diğer çevresel mastitis etmeni olan bakterilerle birlikte ‘gübre mikropları’ da denilmektedir. Diğer türler kadar etkin olmamasına rağmen çevresel mikroorganizmalar adı altında mastitis oluştururlar.
2. 3. Streptococcus Türlerİnİn OluŞturduĞu Enfeksİyonlar. In Patojenİk ve Epİdomİyolojİk Özellİklerİ • Endojen yolla meme enfeksiyonları, mastitis oluşturmaksızın mikroorganizmaların sütle dışa atılımı olayıdır. • Meme başı ekstremitelerinin kontaminasyonu sonucunda meme enfeksiyonları meydana gelir. Belli sayıdaki fiziksel ve kimyasal bariyerler meme kanalında bakterilerin kolonizasyonunu ve penetrasyonunu engeller. • Sağımın dışında bir büzücü kasla ve bizzat sağımda, püskürtme işlemiyle mikroorganizmaların eleminasyonu yapılabiliir. • Kanal boyunca keratin, bakterisid bir etkiye sahipitr. Eğer mikroorganizmalar her kanalda bulunuyorsa elimine edilmezler. Onlar adezyon kapasitelerine göre kanaldaki hücrelere tutunacaklar ve çoğalma gücünde olacaklardır. Daha sonra meme içlerine doğru ilerleyeceklerdir. Sağım sırasında hayvanın hareketi bu bakterileri kanalda tekrar artırır. • Çoğalmaları sırasında sütte salgıladıkları ve oluşturdukları enzim ve toksinlerin üretiminde olan kantitatif ve kalitatif değişimler salgı
Lisozim immunoglobulinler Sütte belirli sayıda antibakteriy el aktif proteinler vardır. Bunlar: Laktoperoksi daz-tiyosiyat. H 2 O 2 sistemi proteinleri Tamamlayıcı sistem proteinleri Fe bağlayıcı proteinler Bunlar gerçekte az etkilidirler. Çünkü konsantrasyonları yetersiz.
2. 4. STREPTOCOCCUS TÜRLERİNİN İDENTİFİKASYONLARI • Kanlı agar üzerinde koloniler küçük, parlaktır. Streptococcus agalactiae kolonileri bu besiyeri üzerinde renksizdir. Streptococcus dysgalactiae’de koloniler kahverengi, Streptococcus uberis, Streptococcus faecalis ve Streptococcus bovis’de ise koloniler az veya çok daha koyu kahverengi renktedir. • Streptococcus türlerinin hepsi katalaz(-), G(+)’dir. • Bu türlerin birbirinden ayrılmasında biyokimyasal ve fizyolojik testlerinde uygulanması gerekir. Son yıllarda ticari kitler ve minyatürize edilmiş biyokimyasal galeriler sayesinde çok daha hızlı idenfikasyon yapılmaktadır. • T. K. T(toksin, kristal viyole, talyum) besiyeri yalnızca streptokokların gelişmesine izin veren besiyeri olduğu için selektiftir. Karışık veya bireysel süt örenklerinin incelenmesinde kullanılmaktadır. Bu ortam üzerinde türlerin ayrımı; eskülinin hidrolizi, Hemoliz ve CAMP testi sayesinde olmaktadır.
2. 5. STREPTOKOK KÖKENLİ MEME ENFEKSİYONLARININ ÖNLENMESİ VE KONTROLÜ Meme enfeksiyonlarının sıklığını azaltmak için, aynı zamanda önceden oluşan enfeksiyon süresini kısaltmak ve yeni enfeksiyonları önlemek gerekir. Başarılı bir mücadele için; ü Mikroorganizmalar tarafından meme başı ve kanalının kolonizasyonu ve geçişini sınırlamak; doğru sağım tekniği, sürü güdümü, iyi bir hijyen uygulaması sağlığı korumak suretiyle olur. ü Enfeksiyona dayanıklı hayvan seçimi ü Etkili işlemlerle yerleşen enfeksiyonları elemine etmek ü Enfeksiyonların elemine etmek veya önlemek için mem seviyesinde defans mekanizmasını stimüle etmek veya yükseltmek ü Koruyucu tedbirlerinin alınması ve hastalığı tedavi sırası gerektiği gibi işlemleri uygulamak, ileri enfeksiyonların önlenmesinde büyük öneme sahiptir.
• Bu tedbirler özellikle; Streptococcus aureus, Streptococcus agalactiae, Streptococcus disagalactiae enfeksiyonlarını önlemede etkin rol oynar.
2. 5. 1. ANTİBİYOTİK TEDAVİSİ: • Antibiyotiğin etkinliği konsantrasyonu, sürekliliği, kullanılan molekülün memede diffüze olma durumuyla ilgilidir. Böylece bakteriyolojik iyileşme oranı, memede 3 -8 hafta gibi uzun zamanda yeniden düzelme sağlayan antibiyotiğin bir katkı maddesi ile birlikte uygulamasıyla yükselir. • Streptococcus agalactiae enfeksiyonlarını başta yarı sentetik veya doğal penisilinle iyileştirme oranın %100’e yakındır. • Bir sürüdeki tüm hayvanların 4 meme başınada uygun dozda antibiyotik uygulayarak Streptococcus agalactiae enfeksiyonlarını tamamen engellemek mümkündür. • Streptococcus disagalactiae ve Streptococcus uberis enfeksiyonları için iyileşme oranı %70 -80 seviyelerindedir. 2. 5. 2 AŞI UYGULAMASI: Aşı ile bir bakteri türlerinin neden olduğu veya streptokoklerin neden olduğu mastitislerin kontrol edilmesi bugün için mümkün değildir. Etkili bir aşıdan doğru olarak beklenen yarar, gelişme güçlüğü sırasına göre, bir taraftan klinik mastitislerin şiddeti ve sıklığını düşürme, diğer taraftan yeni enfeksiyonları düşürme olur.
2. 6. HALK SAĞLIĞI VE SÜTÜN HİJYENİK KALİTESİ ÜZERİNDE STREPTOCOCCUS KÖKENLİ MASTİTİSLERİN ÖNEMİ • Sütte antibiyotik bulunuşu ve somatik hücre sayısı meme enfeksiyonlarının varlığı ve onların etkileri ile direkt ilişkilidir. • Teknolojik işlemler sırasında oluşan olumsuzluklar dışında, insanlarda alerji riski ve bakteri suşlarının seçiminde antibiyotiğe duyarlılığı göz önünde tutulması noktasından hareketle antibiyotiklerin sütte bulunması istenmemektedir. Bunun için sütte bulunan mikroorganizma sayısının belli bir sınırı geçmemesi onların enfeksiyon oluşturmaması bakımından önemlidir. • Mastitis oluşturan streptokoklar arasında yalnızca Streptococcus agalactiae insanlar için önemli bir risk oluşturur. Bunlar septisemi ve menenjitten β streptokoklar, kadın genital sorumlu olan başlıca ajanlardır. organlarında saprofit flora içinde bulunurlar ve yeni doğana bu yolla bulaşır. Bu kontaminasyonun kaynağı bizzat hastane personelidir.